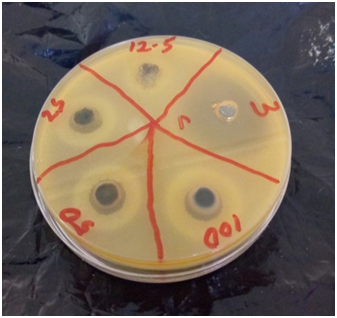
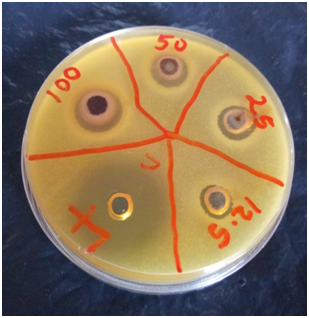
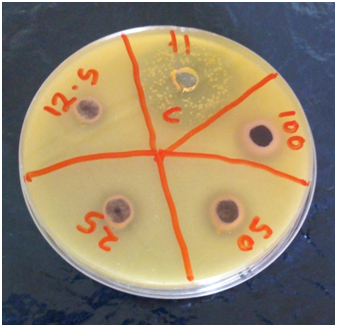

MOJ
eISSN: 2573-2951


Research Article Volume 5 Issue 4
Department of Microbiology, Adekunle Ajasin University, Nigeria
Correspondence: Oludare Temitope Osuntokun, department of microbiology, Adekunle Ajasin University, Akungba Akoko P.M.B 001, Ondo State, Nigeria
Received: June 30, 2018 | Published: August 8, 2018
Citation: Osuntokun OT, Jemilaiye TA, Akinrodoye AR. Comparative study between the effect of Parkia Biglobosa (JACQ) benth and conventional antibiotics against multiple antibiotic resistant uropathogenic bacteria (MARUB). MOJ Bioequiv Availab. 2018;5(4):200-212. DOI: 10.15406/mojbb.2018.05.00103
The purpose of this research work is to compare the effect of convectional antibiotics with medicinal plant (Parkia biglobosa (Jacq.)Benth) against multiple antibiotics resistant Uropathogenic bacteria isolates.(MARUB), which was isolated from basically two hospital in Ondo State, Nigeria. The two hospitals are Gani Fawehinmi Diagnostic center, Ondo and Federal Medical Center, Owo between July, 2017 and October, 2017. fifty two (52) Gram negative bacteria isolated from urine of UTIs patient at the Gani Fawehinmi Medical Diagnostic Centre, Ondo and Federal Medical Centre, Owo were screened for antibiotic resistance assay, The test isolates were identified, characterized with Microbact™ 24E test strip. it was observed that Twenty (20) bacterial isolates were resistant to at least 76.9% (10 out of 13) of the antibiotics tested, showing susceptibility to the carbapenems and piperacillin/Tazobactam. Five (5) isolates were also susceptible to ofloxacin though with narrower diameter zones of inhibition Parkia biglobosa (Jacq.) Benth s a plant used in traditional medicine for the treatment of various diseases in Nigeria. In order to microbiologically appraise some of the traditional and ethno medical uses of Parkia biglobosa, this study aimed at evaluating and compare the diameter zone of inhibition (antibacterial activities) of Parkia biglobosa leaf and stem bark extracts and conventional antibiotic against multiple antibiotic resistant Uropathogenic bacteria (MARUB).
The Parkia biglobosa extracts shows zone of inhibition against Enterobacter agglomerans, Proteus mirabilis, Pseudomonas aeruginosa, Salmonella Subsp. 3B, Serratia marcsesens, Citrobacter freundii and Klebsiella pneumonia. Diameter zones of inhibition range between 8mm to 26mm.respectively. It was observed that Minimum inhibitory concentration (MIC) of Parkia biglobosa extracts against the multiple resistant Uropathogenic bacteria ranges between 6.25mg/ml and 12.5mg/ml for Stem bark and leaf extracts respectively. Pseudomonas aeruginosa has a higher value of Minimum inhibitory concentration (MIC) of Parkia biglobosa of 12.5mg/ml for Stem bark and 25mg/ml for leaf extracts.The major phytochemical constituent of interests such as Polyphenol, Cardiac glycosides, Alkaloids, Tannins Saponin and Flavonoids were found to be present in Parkia biglobosa. In comparing the quantitative content of phytochemical of Parkia biglobosa.Stem bark extract contains large quantity of phytochemical compare to the leaf extract. These constituents are also higher in acetone extract than ethanol extract.These results justifies the uses of Parkia biglobosa in traditional medicine and pave the way for further studies in the developing a new drug.
Keywords:parkia biglobosa (Jacq.)benth, conventional antibiotics, multiple antibiotic resistant uropathogenic Bacteria (MARUB)
Urinary tract infections (UTI) are common infections. It is estimated that 150 million urinary tract infections occur yearly worldwide, resulting in more than six billion dollar in direct healthcare cost.1 Complicated UTIs include those in patients with stones or obstructive Uropathies and in patients with catheter-related infections. Urinary tract infections often contribute to a frequent cause of morbidity in out-patients as well as hospitalized patients.2 These infections are often associated with nosocomial, antibiotic-resistant3 Gram negative and Gram positive bacteria.4 The etiological agents of UTIs are predictable, with Escherichia coli being the commonest pathogen.5 Clinical experience has indicated the presence of numerous cases of antibiotic resistance to common antibiotics by Uropathogens in both developed and developing countries.6 Resistant to newer and more potent antimicrobials are no exceptions but this has decreased the effectiveness of some standard regimes, and thus, the management of urinary tract infections becoming complicated with limited therapeutic options. The emergence of multidrug resistance (MDR) in Uropathogens has further narrowed down the therapeutic options and the need for alternative treatment option. Multidrug resistance (MDR) can be defined as resistance to three or more classes of antibiotics. The increasing incidence of antibacterial resistance and multidrug resistance (MDR) in Uropathogens has highlighted the need to find more alternative antibacterial agents from other sources such as natural products.7
The use of plants as valuable sources of natural products to maintain human and animal health has been in existence for several years. Despite the discovery of modern pharmaceuticals, medicinal plants remain recourse for traditional and natural medicine in several countries.8 Medicinal plants has similar properties as conventional pharmaceutical drugs. These plants have been used by humans throughout history to either cure or alleviate symptoms from an illness. According to the World Health Organization (WHO), a medicinal plant is any plant which, in one or more of its organs contains substances that can be used for therapeutic purposes, or which are precursors for chemo-pharmaceutical semi synthesis. Such a plant will have its parts including leaves, roots, rhizomes, stems, barks, flowers, fruits, grains or seeds, employed in the control or treatment of a disease condition and therefore contains chemical components that are biologically active.9 Parkia biglobosa (Jacq.)Benth is an economic tree found in African savannahs and dry forests. It belongs to the family Fabaceace – pea family, of the order Fabaceae. It is popularly known as the Africa locust bean, Igba or Irugba (Yoruba), Dorowa (Hausa) and Orgili (Ibo ). It is an important multipurpose tree and is well known in many African countries. Apart from providing building materials, wood, food, fodder, weapons and other commodities, Parkia biglobosa plant is especially important as traditional medicine. In Africa, 47% of the various identified uses of Parkia biglobosa were medicinal.10 The fermented seeds of Parkia biglobosa are used in all parts of Nigeria and indeed the west coast of Africa for seasoning traditional soups. The yellow pulp is a high energy giving food with up 60% sugar.11 The trees are often grown as shade trees. Parkia biglobosa have found use traditionally as food and medicinal agent. Depending on the part, the plant is used treating dental caries, pneumonia, bronchitis, violent colic, severe cough, diarrhea, wounds, otitis, dermatoses, amoebiasis, hemorrhoids, bilharziosis, leprosy, hookworms, tracheitis, conjunctivitis.12
The bark is employed in wound healing, treatment of bronchitis, pneumonia, skin infection, sores, ulcer, bilharziasis, malaria, diarrhea and hypertension. In Gambia, the leaves and roots are used in preparing a lotion for sore eyes. A decoctions of the bark of Parkia biglobosa is also used as a bath for fever and as a hot mouth washes to steam and relieve toothache. The pulped bark used along with lemon for wound and ulcer. Fibres from pods and root are used as sponges and as string for musical instrument.13 The powdered pods are used to paint traditional Hausa buildings in northern Nigeria. Parkia biglobosa has been identified as source of tannin, saponins, gum, fuel and wood. Seeds of various species of Parkia have also been investigated for their protein and mineral content.14 Indigenous healers in Africa use different parts of the locust bean tree for health benefits. In a survey conducted on healers in Togo, Parkia biglobosa was one of the highest cited plants used for treating hypertension.15 The tree was also one of two plants “listed as having real wound-healing properties in South-Western Nigeria, influencing the proliferation of dermal fibroblasts significantly.16 In a similar survey conducted in Guinea relating to their use of antimalarial plants, Parkia biglobosa was cited among those most often successfully used.17 In an analysis on the antibacterial properties of the plant, another study found that “these properties compare favourably with those of streptomycin, making it a potential source of compounds used in the management of bacterial infections.18
Collection of Parkia biglobosa (JACQ.) benth
Parkia biglobosa leaves and stem bark were collected at Akungba community in Ondo State. The plant parts were authenticated at the herbarium of the department of plant science and biotechnology Adekunle Ajasin University, Akungba Akoko, Ondo State. Nigeria.
Preparation of Parkia biglobosa (JACQ.) benth extract
Parkia biglobosa leaf and stem bark was washed with sterile water and air dried for 10 days, and then macerated with mortar and pestle to reduce it in to a semi powdered particles. 100g each of the leave and the stem bark were soaked in 400mL of ethanol and acetone for 3 days. After which it was filtered with what man filter paper. The filtrate was evaporated to dryness using rotary evaporator and Ethanol and Acetone crude extracts was thus obtained for antimicrobial screening.
Isolates collection
Forty (40) non-duplicate non-repetitive clinical isolates of urine specimens were recovered from patients using the laboratory services of Gani Fawehinmi Diagnostic center, Ondo and Federal Medical Center, Owo between July, 2017 and October, 2017. The isolates were then transported using prepared Nutrient agar slant to the Microbiology laboratory of Adekunle Ajasin University for further microbiological analysis. The recovered isolates in nutrient agar slants were thus kept in the refrigerator at -4 ⁰C in readiness for further use.
Antibiogram profile of isolates
Antibiotic susceptibility tests were performed to determine the phenotypic resistance patterns of the bacterial isolates to some common antibiotics available in Nigeria. This test was carried out using Kirby-Bauer’s disc diffusion method on Mueller-Hinton agar (CM337-Oxoid, UK).19 The inocula were prepared from the stock cultures which were maintained in nutrient agar slant at 4⁰C and subculture in nutrient broth using a sterilized wire loop. 1ml of 10-⁴ normal saline dilution of a 24 hours broth culture was mixed with 19ml of the agar in a sterile universal bottle and poured into sterile petri dish. The agar Plate 1a,1b,1c & 1d was left to solidify and the antibiotic discs were thus placed on the agar surface at minimum of 22mm apart and were incubated overnight at 37°C. The diameter of zones of inhibition were measured and recorded in millimeter and the results interpreted according to the Clinical Laboratory Standard Institute20 guidelines. The choice of antibiotics was based on their mechanism of action on bacteria and also on the principle of the commonly prescribed antibiotics in Nigeria’s Tertiary Health Institutions. The standard antibiotic discs (Oxoid, UK) used with their concentrations include Ceftazidime(30µg), Cefoxitin(30µg), Cefotaxime(30µg), Amoxycillin+Clavullanic acid(30µg), Cotrimoxazole (25µg), Ofloxacin(5µg), Imipenem(10µg), Piperacillin/Tazobactam(110µg), Cloxacillin(5µg), Oxacillin(1µg), Piperacillin(100µg), Meropinem(10µg), Vancomycin(30µg), Teicoplanin(30µg) and Nystatin(100iu). Isolates resistant to three or more classes of antibiotics were considered multiple drug resistant bacteria.
Identification of multiple drug resistant bacteria isolates
Preliminary confirmatory test to identify the multiple drug resistant isolates was thus performed using Oxidase strips and Microbact™ 24E (Oxoid, UK) identification kits according to the manufacturer’s instruction. 4 drops of the 104 bacterial broth dilutions were added to each of the 24 wells in the test strip. Few wells were overlaid with mineral oil and thus incubated for 24 hours. Reagents were added to few wells and the colour changes were recorded in the report forms, result codes generated and were inputted into the software where the probable organism is displayed.
Antimicrobial screening of Parkia biglobosa (JACQ.)benth (measuring the zones of inhibition)
The antimicrobial screening of the Parkia biglobosa extracts against the multiple drug resistant isolates was carried out using the agar well diffusion method. A stock concentration of 100mg/ml was constituted by dissolving 1g each, of the extracts in 10ml of Dimethyl sulfoxide (DMSO) diluted with sterile distilled water in ratio 1:3.50mg/ml, 25mg/ml and 12.5mg/ml concentrations of the extracts were the prepared using dilution formula (C1V1=C2V2). 1ml of 10-⁴ normal saline dilution of a 24 hours broth culture was mixed with 19ml of the agar in a sterile universal bottle and poured into sterile petri dish. The agar Plate 2a, 2b was left to solidify and wells were bored on them using 6mm cork borer. 50µl of each concentration of the extracts was poured into each well and incubated at 37 °C for 24 hours. The diameter zones of inhibition were measured and recorded in millimeter and the results interpreted according to the Clinical Laboratory Standard Institute21 guidelines. Levofloxacin (0.125mg/ml) and Demethyl sulfoxide were used as positive and negative controls Plate 3a, 3b, 3c & 3d.

Determination of minimum inhibitory concentration (MIC) and minimum bactericidal concentration (MBC)
The MIC of the extracts against the antibiotic resistant organisms was determined using the tube dilution method.22 A stock concentration of 200mg/ml was constituted by dissolving 2g each, of the extracts in 20ml of Dimethyl sulfoxide (DMSO) diluted with sterile distilled water in ratio 1:3. Using Mueller Hinton broth as the diluent, 100mg/ml, 50mg/ml, 25mg/ml and 12.5mg/ml were prepared from the stock solution in separate sterile test tubes. Then 1ml of the standardized broth suspension (10-4) was inoculated into each test tube and mixed thoroughly. The test tubes were then incubated at 37 °C for 24hours. The lowest concentration with no detectable growth was considered as the MIC. The MBC of the plant against the isolates was determined by sub culturing the test dilutions onto a fresh solid medium and incubated further for 18-24hour. The highest dilution that yielded no bacterial growth on solid medium was taken as MBC23
Qualitative phytochemical analysis of Parkia biglobosa (JACQ.) benth
Test for reducing sugars
One milliliter of the Parkia biglobosa filtrate was mixed with Fehling A and Fehling B separately; a brown colour with Fehling B and a green colour with Fehling A indicate the presence of reducing sugars.24
Test for alkaloids
Wet the powdered test samples of Parkia biglobosa with a half diluted NH4OH and lixiviated with EtOAc for 24hr at room temperature. Separate the organic phase from the acidified filtrate and basify with NH4OH (pH 11-12). Then Parkia biglobosa extract it with chloroform (3X), condense by evaporation and use for chromatography. Separate the alkaloid spots using the solvent mixture chloroform and methanol (15:1). Spray the spots with Dragendorff’s reagent. Orange spot shows is a positive result.25
Test for anthraquinone
Borntrager's test
Heat about 50mg of Parkia biglobosa extract with 1ml 10% ferric chloride solution and 1ml of concentrated hydrochloric acid. Cool the extract and filter. Shake the filtrate with equal amount of diethyl ether. Further extract the ether extract with strong ammonia. Pink or deep red colouration of the aqueous layer indicates anthraquinone presence.26,27
Test for cardiac glycosides
Extract the powdered test samples of Parkia biglobosa with 70% EtOH on rotary shaker (180thaws/min) for 10hr. Add 70% lead acetate to the filtrate and centrifuge at 5000rpm/10 min. Further centrifuge the supernatant by adding 6.3% Na2CO3 at 10000 rpm/10min. Dry the retained supernatant and re-dissolved in chloroform and use for chromatography. Separate the glycosides using EtOAc-MeOH-H2O (80:10:10) solvent mixture. The colour and hrf values of these spots can be recorded under ultraviolet (UV254 nm) light (26:27).
Test for flavonoid
Extract 1g powdered test samples of Parkia biglobosa with 10ml methanol on water bath (60°C/5min). Condense the filtrate by evaporation, and add a mixture of water and EtOAc (10:1mL), and mix thoroughly. Retain the EtOAc phase and use for chromatography. Separate the flavonoid spots using chloroform and methanol (19:1) solvent mixture. The color and hRf values of these spots can be recorded under ultraviolet (UV254nm) light (26;27:28)
Test for phenol
Phenol test Spot the Parkia biglobosa extract on a filter paper. Add a drop of phoshomolybdic acid reagent and expose to ammonia vapors .Blue coloration of the spot, shows is a positive result.28
Test for saponin
Extract two grams of powdered Parkia biglobosa test samples with 10 ml 70% EtOH by refluxing for 10 min. Condense the filtrate, enrich with saturated n-BuOH, and mix thoroughly. Retain the butanol, condense and use for chromatography. Separate the saponins using chloroform, glacial acetic acid, methanol and water (64:34:12:8) solvent mixture. Expose the chromatogram to the iodine vapors. The colour (yellow) and hRf values of these spots were recorded by exposing chromatogram to the iodine vapours.28,29
Test for steroid
Extract two grams of powdered Parkia biglobosa test samples with 10ml methanol in water bath (80 °C/15 min). Use the condensed filtrate for chromatography. The sterols can be separated using chloroform, glacial acetic acid, methanol and water (64:34:12:8) solvent mixture. The color and hRf values of these spots can be recorded under visible light after spraying the plates with anisaldehyde-sulphuric acid reagent and heating (100 °C/6 min)The color (Greenish black to Pinkish black) and hRf values of these spots can be recorded under visible light.29
Test for Tannin
Braemer’s test 10% alcoholic ferric chloride will be added to 2-3ml of methanolic extract (1:1) Dark blue or greenish grey coloration of the solution.29
Quantitative method of analyses of Parkia biglobosa (JACQ.) benth
Estimation of saponins
About 20grams each of dried Parkia biglobosa samples were ground and, put into a conical flask after which 100ml of 20% aqueous and ethanol were added. The mixture was heated using a hot water bath at 55 °C, for 4 hours with continuous stirring, after which the mixture was filtered and the residue re-extracted further with a 200ml of 20% ethanol. The combined extracts were reduced to 40ml over a water bath at 90 °C. The concentrate was transferred into a 250ml separation funnel and 20ml of diethyl ether was added and then shaken vigorously. The aqueous layer was recovered while the ether layer was discarded. The purification process was repeated three times. Then 60rnl of n-butanol was added. The combined n-butanol extracts were washed twice with 10 m1 of 5% aqueous sodium chloride. The remaining solution was heated in a water bath. After evaporation, the samples were dried in the oven to a constant weight; the saponin content was calculated as percentage of the starting material.30,31
Estimation of total flavonoid concentration
The concentration of flavonoids in the Parkia biglobosa extract was estimated spectrophotometrically according to the procedure of32 The extract (0.1g) was dissolved in 20ml of 70% (v/v) ethanol to give a final concentration of 0.5mg/ml. To clean dry test tubes (in triplicate) were pipetted 0.5 ml of working solution of sample and diluted with 4.5 ml distilled water. To each test tube was added 0.3 ml of 5% (w/v) NaNO2, 0.3ml of 10% Aid3 and 4ml of 4% (w/v) NaOH. The reaction mixtures were incubated at room temperature for 15minutes. The absorbance was read at 500nm against reagent blank. The standard calibration curve was prepared by pipetting 0.2, 0.4, 0.6, 0.8, 1.0ml of 1mg/ml rutin into clean dry test tubes. The volumes were made up to 5ml with distilled water. To each of the tubes were added 0.3ml of 5% (w/v) NaNO2, 0.3ml of 5% (w/v) Aid3 and 4ml of 4% (w/v) NaOH. The reaction mixture was incubated at room temperature for 15min. Absorbance was taken at 500nm and was plotted against the concentration to give the standard calibration curve. The concentrations of the flavonoids in the extract was extrapolated from standard calibration curve and expressed as milligram rutin equivalent per g of extract (mg RE/g extract).31–33
Estimation of cardiac glucosides (borntrager’s test)
To 2ml of filtrate hydrolysate, 3ml of ethylacetate was added and shaken, ethyl acetate layer was separated and 10% ammonia solution was added to it. Formation of pink color indicated the presence of anthroquinone glycosides.34
Detection of alkaloid content
Five grams of the Parkia biglobosa sample was weighed into a 250ml beaker and 200ml of 10% acetic acid in ethanol was then added. The reaction mixture was covered and allowed to stand for 4hour. This was filtered and the extract was concentrated on a water bath to one-quarter of the original volume. Concentrated ammonium hydroxide was added drop-wise to the extract until the precipitation was completed. The whole solution was allowed to settle and the precipitate was collected, washed with dilute ammonium hydroxide and then filtered; the residue being the alkaloid was dried and weighed to a constant mass.31–35
Estimation of phlobatannins
About 0.5grams of each Parkia biglobosa extracts was dissolved in distilled water and filtered. The filtrates were boiled in 2%HCl, Red precipitate showed the presence of phlobatannins.36
Estimation of total phenolic concentration
Estimation of total phenolic content was carried out using Folin-Ciocalteu’s phenol reagent reaction as reported by.37 The assay involved pipetting 0.2, 0.4, 0.6, 0.8, 1.0ml of garlic acid solution (1.0mg/I) in triplicate in clean dried test tubes. The volumes were made up to 1.0ml with distilled water. To each of the test tube was added 1.5 ml of 10% (w/v) NaHCO3 solution to give a total volume of 4.0ml. The reaction mixtures were further incubated for additional one and half hours. The estimation of phenol in ethanolic extract of Parkia biglobosa involved pipetting 0.5ml each of 5mg/mI ethanolic extract into clean dry test tubes in triplicate. The volumes were adjusted to 1.0 ml with distilled water. To each of the tubes was added 1.5ml of Folin-Ciocalteu’s phenol reagent (1:10). The reaction mixture was incubated at room temperature for 5mimutes. To the reaction mixture was added 5 ml of 10% (w/v) NaHCO3 solution. The reaction mixture was incubated for one and half hour. The absorbance was read at 725nm against the blank containing all reagents except the standard gallic acid. The absorbance at 725nm was plotted against the concentration to produce the standard curve. The concentrations of the phenolies in the extract was extrapolated from standard curve and expressed as milligram tannic acid equivalent per g of extract (mg TAE/g extract).38
Determination of tannins
About 500mg of the Parkia biglobosa sample were weighed into a 50-ml plastic bottle. 50ml of distilled water was added and shaken for 1hour on a mechanical shaker. This was filtered into a 50-ml volumetric flask and made up to the marked level. Then, 5ml of the filtrate was transferred into a test tube and mixed with 2ml of 0.1M FeCl in 0.1MHcl and 0.008M potassium ferrocyanide. The absorbance was measured at 120nm within 10minutes. The tannins content was calculated using a standard curve of extract.39 Figure 1 & 2
Table 1 shows the antibiotic susceptibility pattern of the twenty (20) Uropathogenic bacteria that were resistant to virtually all the antibiotics tested. All the isolates (100%) were susceptible to Piperacillin/Tazobactam. 90% (18 out of 20) of the isolates were susceptible to the Carbapenems (Imipenem and Meropenem) while 50 %(5 out of 20) were inhibited by Ofloxacin.
Antiobiotic (concentration in µg) |
|
|
|
|
|
|
|
|
|
|
|||
Isolate |
CAZ(30µg) |
FOX(30µg) |
CFX(30µg) |
SXT(25µg) |
OF(5µg) |
IPM(10µg) |
TZP(110µg) |
OB(5µg) |
OX(1µg) |
PRN(100µg) |
AMC(30µg) |
MEM(10µg) |
NS(100µg) |
GF 1 |
0 |
0 |
0 |
0 |
0 |
20 |
24 |
0 |
0 |
0 |
0 |
24 |
0 |
GF 2 |
0 |
0 |
0 |
0 |
14 |
22 |
18 |
0 |
0 |
0 |
0 |
18 |
0 |
GF 3 |
0 |
17 |
0 |
0 |
0 |
18 |
18 |
0 |
0 |
0 |
0 |
21 |
0 |
GF 4 |
0 |
17 |
0 |
0 |
0 |
16 |
20 |
0 |
0 |
0 |
0 |
22 |
0 |
GF 5 |
0 |
0 |
0 |
0 |
0 |
22 |
16 |
0 |
0 |
0 |
0 |
16 |
0 |
GF 6 |
0 |
0 |
0 |
0 |
18 |
0 |
12 |
0 |
0 |
0 |
0 |
0 |
0 |
GF 7 |
0 |
0 |
0 |
0 |
0 |
22 |
19 |
0 |
0 |
0 |
0 |
14 |
0 |
GF 8 |
0 |
0 |
0 |
0 |
0 |
18 |
16 |
0 |
0 |
0 |
0 |
20 |
0 |
FM 1 |
0 |
0 |
0 |
0 |
0 |
24 |
20 |
0 |
14 |
0 |
0 |
18 |
0 |
FM 2 |
0 |
0 |
0 |
0 |
18 |
18 |
20 |
0 |
0 |
0 |
0 |
24 |
0 |
FM 3 |
0 |
0 |
0 |
0 |
0 |
21 |
24 |
0 |
0 |
0 |
0 |
12 |
0 |
FM 4 |
0 |
0 |
0 |
0 |
0 |
16 |
12 |
0 |
0 |
0 |
0 |
19 |
0 |
FM 5 |
0 |
0 |
0 |
0 |
0 |
12 |
18 |
0 |
0 |
0 |
0 |
20 |
0 |
FM 6 |
0 |
0 |
0 |
0 |
16 |
18 |
20 |
0 |
0 |
0 |
0 |
18 |
0 |
FM 7 |
0 |
0 |
0 |
0 |
0 |
0 |
18 |
0 |
0 |
0 |
0 |
24 |
0 |
FM 8 |
0 |
0 |
0 |
0 |
0 |
20 |
18 |
0 |
0 |
0 |
0 |
17 |
0 |
FM 9 |
0 |
0 |
0 |
0 |
0 |
16 |
20 |
0 |
0 |
0 |
0 |
24 |
0 |
FM 10 |
0 |
0 |
0 |
0 |
0 |
20 |
18 |
0 |
0 |
0 |
0 |
32 |
0 |
FM 11 |
0 |
0 |
0 |
0 |
0 |
18 |
20 |
0 |
0 |
0 |
0 |
24 |
0 |
FM 12 |
0 |
0 |
0 |
0 |
18 |
14 |
16 |
0 |
0 |
0 |
0 |
28 |
0 |
Table 1 Antibiogram profiles of multiple antibiotic resistant uropathogenic bacteria isolates (MARUB). (Measured of zones of inhibition in mm)±SEM
AMC, amoxicillin clavulanic acid; CAZ, ceftazidime; CTX, cefotaxime; MEM, meroprnem; VA, vancomycin; FOX, cefoxitin; TZP, piperacillin/taxobactam; SXT, sulphamethoxazole/trimethoprin; IPM, imepenem
Table 2 shows the probable phenotypic identity of the bacterial isolates using Microbact™ 24E (Oxoid, UK) Identification kit. Among the twenty (20) multiple antibiotic resistant isolates, Proteus mirabilis and Enterobacter agglomerans were three (3) each. Others were Klebsiella sp., Escherichia coli, Salmonella Supsp. 3B, Pseudomonas aeroginosa, Citrobacter freundii, Acinetobacter baumanii and Serratia marcesens.
Isolate |
Result test code |
Probable Identity |
% probability |
GF 1 |
40562040 |
Stenotrophomonas maltophilia |
99.4 |
GF 2 |
7574543 |
Enterobacter agglomerans |
98.68 |
GF 3 |
70736002 |
Moraxella morganii |
98.27 |
GF 4 |
7611776 |
Enterobacter agglomerans |
98.04 |
GF 5 |
44734051 |
Providentia stuartii |
88.28 |
GF 6 |
55722020 |
Acinetobacter baumanii |
98.7 |
GF 7 |
11576001 |
Proteus mirabilis |
99.99 |
GF 8 |
34576041 |
Proteus mirabilis |
99.99 |
FM 1 |
75776661 |
Salmonella Subsp. 3B |
81.88 |
FM 2 |
703306001 |
Pseudomonas aeruginosa |
98.9 |
FM 3 |
72522261 |
Salmonella Subsp. 3B |
82.01 |
FM 4 |
71566541 |
Serratia marscesens |
98.95 |
FM 5 |
56576200 |
Enterobacter agglomerans |
99.64 |
FM 6 |
14311342 |
Proteu vulgaris |
99.84 |
FM 7 |
17430765 |
Citrobacter freundii |
99.46 |
FM 8 |
66603562 |
Escherichia coli |
96.26 |
FM 9 |
14176000 |
Proteus mirabilis |
99.94 |
FM 10 |
47760756 |
Klebsiella oxytoca |
99.58 |
FM 11 |
57560776 |
Klebsiella pneumonia |
99.71 |
FM 12 |
46203560 |
Escherichia coli |
92.23 |
Table 2 Phenotipic identity of the organisms using microbact™ 24E (Oxoid, UK) Identification kit
Table 3 shows the antibacterial activity of Parkia biglobosa leaf and stem extracts against the multiple resistant Uropathogenic Bacteria isolates. The all bacteria were susceptible to the medicinal plant. They are Enterobacter agglomerans, Proteus mirabilis, Pseudomonas aeruginosa, Salmonella Subsp. 3B, Serratia marcsesens, Citrobacter freundii and Klebsiella pneumonia with diameter zones of inhibition ranging from 8mm to 26mm.
|
Leaf (Ethanolic extract) |
Leaf(acetone extract) |
Stem bark (Ethanolic extract) |
Stem bark(acetone) |
||||||||||||
|
100mg/ml |
50mg/ml |
25mg/ml |
12.5 mg/ml |
100 mg/ml |
50 mg/ml |
25 mg/ml |
12.5 mg/ml |
100 mg/ml |
50 mg/ml |
25 mg/ml |
12.5 mg/ml |
100mg/ml |
50mg/ml |
25mg/ml |
12.5mg/ml |
GF1 Stenotrophomonas maltophilia |
20 |
14 |
10 |
8 |
18 |
14 |
10 |
6 |
19 |
15 |
10 |
9 |
21 |
15 |
10 |
8 |
GF2 Enterobacter agglomerans |
21 |
10 |
5 |
2 |
21 |
14 |
10 |
6 |
10 |
8 |
5 |
3 |
23 |
17 |
10 |
7 |
GF3 Moraxella morganii |
23 |
15 |
10 |
7 |
23 |
18 |
10 |
7 |
20 |
16 |
15 |
10 |
24 |
18 |
10 |
6 |
GF 4 Enterobacter agglomerans |
18 |
10 |
6 |
5 |
18 |
10 |
7 |
5 |
18 |
16 |
12 |
8 |
20 |
18 |
12 |
8 |
GF5 Providentia stuartii |
20 |
10 |
8 |
4 |
20 |
10 |
8 |
5 |
20 |
15 |
10 |
7 |
10 |
8 |
5 |
4 |
GF6 Acinetobacter baumanii |
23 |
17 |
10 |
8 |
21 |
16 |
10 |
8 |
18 |
14 |
10 |
5 |
21 |
17 |
10 |
5 |
GF7 Proteus mirabilis |
20 |
18 |
16 |
10 |
10 |
8 |
8 |
5 |
23 |
22 |
16 |
14 |
25 |
22 |
18 |
12 |
GF8 Proteus mirabilis |
20 |
15 |
10 |
8 |
21 |
15 |
10 |
7 |
20 |
10 |
8 |
5 |
21 |
16 |
12 |
10 |
FM1 Salmonella Subsp. 3B |
20 |
15 |
10 |
7 |
17 |
10 |
8 |
6 |
20 |
15 |
10 |
7 |
10 |
8 |
6 |
5 |
FM2 Pseudomonas aeruginosa |
18 |
16 |
12 |
8 |
20 |
15 |
13 |
8 |
22 |
20 |
18 |
15 |
24 |
21 |
18 |
12 |
FM3 Salmonella Subsp. 3B |
20 |
18 |
12 |
8 |
20 |
18 |
12 |
8 |
26 |
24 |
22 |
18 |
26 |
24 |
24 |
20 |
FM4 Serratia marscesens |
15 |
14 |
14 |
10 |
13 |
10 |
8 |
5 |
22 |
21 |
18 |
12 |
26 |
24 |
22 |
15 |
FM5 Enterobacter agglomerans |
20 |
18 |
10 |
6 |
21 |
18 |
10 |
6 |
23 |
18 |
17 |
10 |
24 |
17 |
10 |
8 |
FM6 Proteu vulgaris |
13 |
10 |
9 |
5 |
20 |
18 |
10 |
5 |
26 |
19 |
10 |
5 |
22 |
16 |
10 |
8 |
FM7 Citrobacter freundii |
18 |
10 |
9 |
6 |
18 |
8 |
6 |
4 |
18 |
18 |
12 |
8 |
20 |
18 |
12 |
8 |
FM8 Escherichia coli |
10 |
10 |
7 |
5 |
20 |
10 |
8 |
6 |
20 |
10 |
4 |
2 |
10 |
9 |
6 |
2 |
FM9 Proteus mirabilis |
23 |
18 |
10 |
3 |
20 |
10 |
10 |
7 |
23 |
16 |
10 |
3 |
15 |
10 |
9 |
3 |
FM10 Klebsiella oxytoca |
20 |
10 |
3 |
2 |
10 |
5 |
3 |
0 |
10 |
6 |
3 |
2 |
16 |
9 |
7 |
5 |
FM11 Klebsiella pneumonia |
20 |
18 |
12 |
8 |
20 |
18 |
12 |
8 |
26 |
24 |
22 |
18 |
26 |
24 |
24 |
20 |
FM12 Escherichia coli |
10 |
5 |
5 |
2 |
20 |
18 |
10 |
7 |
10 |
7 |
6 |
5 |
20 |
10 |
9 |
5 |
Table 3 Antimicrobial activity (zone of inhibition) of parkia biglobosa (Jacq.)benth against multiple Aantibiotic resistant uropathogenic bacteria isolates (MARUB)
Table 4 shows the MIC values of the plant Extracts against the susceptible Uropathogenic bacteria isolates. The MIC values were 6.25mg/ml and 12.5mg/ml for stem bark and leaf respectively regardless of the solvent used. That against Pseudomonas aeruginosa was 12.5mg/ml and 25mg/ml respectively for stem bark and leaf, which is higher than average.
|
Leaf(Ethanolic extract) |
Leaf(acetone extract) |
Stem bark(Ethanolic extract) |
Stem bark(acetone) |
||||||||||||
|
25mg/ml |
12.5mg/ml |
6.25 mg/ml |
3.125 mg/ml |
25mg/ml |
12.5mg/ml |
6.25 mg/ml |
3.125 mg/ml |
25mg/ml |
12.5mg/ml |
6.25 mg/ml |
3.125 mg/ml |
25mg/ml |
12.5mg/ml |
6.25 mg/ml |
3.125 mg/ml |
GF4 Enterobactr agglomeras |
- |
- |
+ |
+ |
- |
- |
+ |
+ |
- |
- |
- |
+ |
- |
- |
- |
+ |
GF7 Proteus mirabilis |
- |
- |
+ |
+ |
- |
- |
+ |
+ |
- |
- |
- |
+ |
- |
- |
- |
+ |
FM2 Proteus mirabilis |
- |
+ |
+ |
+ |
- |
+ |
+ |
+ |
- |
- |
- |
+ |
- |
- |
- |
+ |
FM3 Salmonella Subsp. 3B |
- |
- |
+ |
+ |
- |
- |
+ |
+ |
- |
- |
- |
+ |
- |
- |
- |
+ |
FM4 Serratia marscesens |
- |
- |
+ |
+ |
- |
- |
+ |
+ |
- |
- |
- |
+ |
- |
- |
- |
+ |
FM7 Citrobacter freundii |
- |
- |
+ |
+ |
- |
- |
+ |
+ |
- |
- |
- |
+ |
- |
- |
- |
+ |
FM11 Klebsiella pneumonia |
- |
- |
+ |
+ |
- |
- |
+ |
+ |
- |
- |
- |
+ |
- |
- |
- |
+ |
Table 4 The MIC values of the parkia biglobosa (Jacq.)benth extracts against the multiple antibiotic resistant uropathogenic bacteria isolates (MARUB)
No growth (-), growth (+); leaf-(ethanol and acetone extracts) MIC -6.25mg/ml; MBC-3.125mg/ml; stem bark-(ethanol and acetone extracts) MIC-12.5mg/ml; MBC-6.25mg/ml
Table 5 shows the qualitative phytochemical analysis of the extracts of Parkia biglobosa. All the phytochemical screened for were present in the extracts, though varies among the extracts. These include Alkaloids, Cardiac glycosides, Steroids, Phenol, Flavonoids, Tannins, Saponin and Reducing sugar.
|
Leaf |
Stem bark |
||
|
Ethanol extract |
Acetone extract |
Ethanol extract |
Acetone extract |
Alkaloids |
+ve |
+ ve |
+ ve |
+ ve |
Cardiac glycoside |
+ ve |
- ve |
+ ve |
+ ve |
Steroids |
- ve |
+ ve |
- ve |
+ ve |
Anthraquinone |
+ ve |
- ve |
ND |
+ ve |
Phenol |
+ ve |
+ ve |
- ve |
+ ve |
Tannins |
+ ve |
+ ve |
+ ve |
+ ve |
Saponin |
+ ve |
- ve |
- ve |
+ ve |
Flavonoids |
- ve |
+ ve |
+ ve |
- ve |
Reducing sugar |
+ ve |
- ve |
- ve |
+ ve |
Table 5 Qualitative phytochemical screening of ethanol and acetone extracts of parkia biglobosa (Jacq.) benth
Positive +ve; Negative –ve; ND = Not Detected
Table 6 shows the quantitative phytochemical screening of ethanol and acetone extracts of Parkia biglobosa. Phytochemicals present were higher in amount in acetone extracts than in ethanol extract
|
Leaf |
Stem bark |
||
|
Ethanol extract |
Acetone extract |
Ethanol extract |
Acetone extract |
Alkaloids |
2.42 |
3.69 |
3.5 |
13.89 |
Phlobatamins |
1.9 |
13.7 |
3.211 |
14.01 |
Cardiac glycoside |
2.21 |
4.7 |
3.54 |
6.49 |
Phenol |
2.11 |
6.55 |
3.59 |
9.75 |
Tannins |
2.35 |
1.5 |
3 |
10.26 |
Saponin |
2.28 |
1 |
3.58 |
11.23 |
Flavonoids |
1.9 |
2.31 |
3.2 |
9.34 |
Table 6 Quantitative phytochemical screening of ethanol and acetone extracts of parkia biglobosa (Jacq.)Benth
The purpose of this research work is to compare the activity and effect of convectional antibiotics with medicinal plant against multiple antibiotics resistant Uropathogenic bacteria isolates (MARUB), which was isolated from basically from two hospitals in Ondo State, Nigeria. The hospitals are Gani Fawehinmi Diagnostic center, Ondo and Federal Medical Center, Owo between July, 2017 and October, 2017. The medicinal plant under study are the leaf and stem bark extract of Parkia biglobosa ,which is one of the medicinal plant used for the treatment of various infection in Africa and Southwestern part of Nigerian. The scope of the research work was extended to the determination of qualitative and quantitative phytochemical constituent of the Parkia biglobosa and the result was very remarkable and commendable because of the various observable activity of the Parkia biglobosa agasint clinical isolates.
In this study, fifty two (52) Gram negative bacteria isolated from urine of UTIs patient at the Gani Fawehinmi Medical Diagnostic Centre, Ondo and Federal Medical Centre, Owo were screened for antibiotic resistance assay. The isolates shows high prevalence of multiple antibiotic resistance of the test isolates. Twenty (20) bacterial isolates were resistant to at least 76.9% (10 out of 13) of the antibiotics tested, exhibiting susceptibility to the Carbapenems and Piperacillin/Tazobactam. Five (5) isolates were also susceptible to Ofloxacin though with narrower diameter zones of inhibition (Table 1). These bacteria include Enterobacter agglomerans, Proteus spp., Pseudomonas aeruginosa, Klebsiella spp., Acinetobacter baumanni, and Serratia marscesens. This is similar to the report of Kumar et al.33 That isolated multiple drug resistant Proteus sp., Pseudomonas sp., and Enterobacter sp. from urine samples of UTI patients.40
High prevalence of multidrug resistance indicates serious need for review of antibiotics administration policy. Multiple antibiotic resistance (MAR) analysis has been used to differentiate bacteria from different sources using antibiotics that are commonly used for human therapy. Despite the attendant significant morbidity associated with Uropathogenic bacterial, the increasing rates of resistance in them, makes it more difficult for them to be treated with cheaper first line antibiotics. Emerging and increasing resistance to newer and otherwise efficacious antibiotics may compound the whole problem.41–43 reported that Enterobacter agglomerans, Proteus spp., Pseudomonas aeruginosa, Klebsiella spp., Acinetobacter baumanni, Serratia marscesens and E.coli pathogen is the most common pathogens of UTIs in the male and female surgical ward in some hospital. This high incidence of the E coli and other pathogenic bacteria could be attributed to the fact that it is a commensal of the bowel and that infection is mostly by feacal contamination due to poor hygiene. This is owed to the fact that commensals of the intestines are more involved in the UTIs because of the anatomy proximity to the genitourinary area.
Other pathogens isolated in order of prevalence include Klebsiella spp. Proteus mirabilis, P aeruginosa, Enterobacter aerogenes, Citrobacter freundii. This also revealed that the isolated pathogens in this study were coliforms which are index organism of safety, good hygiene and sanitary quality. This conforms to the report of43 that the dominant etiologic agents accounting for more than 85% of cases of UTIs are the Gram-negative Bacilli which are normal flora of the intestinal tract, Escherichia coli, Klebsiella pneumoniae, Pseudomonas aeruginosa, Enterobacter.44 Who reported that opportunistic and systemic pathogens that cause UTI are resistant to most antibiotics and makes them difficult to treat, this is one of the reasons why medicinal plan is an alternative source of treatment of UTI and infection alike.
Parkia biglobosa (JACQ.) Benth which is a plant used in traditional pharmacopoeia has shown variable antibacterial activities according to the extracts. Antimicrobial screening of Parkia biglobosa shows that both the ethanol and acetone extracts of the leaf and stem bark inhibits all of the multiple antibiotic resistant Uropathogens. The bacteria are Enterobacter agglomerans, Proteus mirabilis, Pseudomonas aeruginosa, Salmonella Subsp. 3B, Serratia marcsesens, Citrobacter freundii and Klebsiella pneumonia. The diameter zones ranges from 8mm to 26mm with wider zones recorded against Serratia marscesens, Salmonella Subsp. 3B and Klebsiella pneumoniae for Acetone extracts (Table 3). The acetone extracts showed more activities than the ethanol extracts as indicated in their diameter zones of inhibition. The ethanol extracts are less effective than the ethyl acetate extracts with the studied strains.
The high efficiency observed with the acetone extracts is similar to the results observed by44 with Parkia biglobosa acetone extract against Salmonella typhimurium.45 These observations can be explained by the affinity of phytomolecules for solvents. The antibacterial substances contained in P. biglobosa are then more soluble in acetone than in polar solvent. The stem bark extracts were more active than the leave extracts. This difference can be explained by difference of physiological characteristics of a plant according to its maturity, the soil nature and the environmental microclimate. These factors are very important in the chemical principles biosynthesis and, therefore, influence the plant pharmacological activity.45 The results also shows that at a concentration of 6.25mg/ml and 12.5mg/ml for stem bark and leaf respectively, Parkia biglobosa had antimicrobial activity on the susceptible multiple antibiotic resistant bacteria regardless of the solvent used for extraction (Table 4). The MIC against Pseudomonas aeruginosa was however higher (12.5mg/ml for stem bark and 25mg/ml for leaf).46 reported MIC value of 3.125mg/ml for stem bark extract against Shigella sp.
Phytochemical screening indicates that most of the phytoconstituents tested for were present in the Acetone extract of the stem bark except flavonoids. While anthraquinone was not detected in the stem bark ethanol extracts, Alkaloids, cardiac glycosides, steroids, phenol, tannins, saponin and reducing sugar were all present (Table 5). Quantitative analysis showed higher amount of phytochemicals in the acetone extracts than in the ethanol extracts (Table 6). This shows the generality of the components in medicinal plants. Biological actions are primarily due to these components in a very complicated concert of synergistic or antagonistic activities. Mixtures of such chemicals show a broad spectrum of biological effects and pharmacological properties. To a large extent, the phonological age of the plant, percentage humidity of the harvested material, situation and time of harvest, and the method of extraction are possible sources of variation for the chemical composition, toxicity and bioactivity of the extracts.46
The most remarkable and observable inference that can be drawn from his research work is that, the medicinal plant, Parkia bigblosa has an outstanding effect and overwhelming activity on multiple resistant antibiotic Uropathogenic bacterial (MARUB) compare with the convectional antibiotics, this can be attributed to the presence of phytochemical which plays a lot of inhibitory role in the inhibition and destruction of multiple resistant antibiotic uropathogenic bacterial (MARUB) by destroying the microorganism intracellular membrane, which has the ability to create pores on the plasma membrane of Uropathogenic organism, due to this fact, this plant can be recommended for use in various phases for treatment of infectious diseases.47
The medicinal uses of Parkia biglobosa (JACQ.)Benth should mention, to show the efficacious nature of Parkia bigblosa, The bark is used as a mouthwash, vapour inhalant for toothache, or for ear complaints. It is macerated in baths for leprosy and used for bronchitis, pneumonia, skin infections, sores, ulcers, bilharzia, washes for fever, malaria, diarrhoea, violent colic and vomiting, sterility, venereal diseases, guinea worm, oedema and rickets, and as a poison antidote. An alcoholic extract of crude seeds showed anti-hypertensive activity and contractile effect on smooth muscles of the intestine, and increased the tonus and mobility of the uterus.47 The richness of the leaf in phenolic compounds indicate that it might have antimicrobial effects. Indeed, in Burkina Faso, even if the bark is the most commonly used, the traditional practitioners also use effectively the leaf for the treatment of some infectious diseases.36 Reported that leaves of Parkia biglobosa (JACQ.) Benth. Were used externally for the treatment of bronchitis, dermatosis, and filariosis and per os for the treatment of stomachaches and parasitosis.46
The present work made enable to underline the antimicrobial properties of Parkia biglobosa leaf and stem bark extracts. Parkia biglobosa have high-dose antimicrobial activity against multiple antibiotic resistant bacteria. These extracts (acetone and ethanol) have bactericidal and bacteriostatic effects. This study, beyond its long-term objectives of revealing new anti-infectious molecules, is above all a validation of the use of this plant in traditional medicine. Thus, Parkia biglobosa extracts may be considered after further complementary studies in ethno pharmacological use for the treatment of urinary tract infection.
The authors wish to express their appreciation to all the technical staffs of the laboratory unit of both the Department of Microbiology, Faculty of Science, Adekunle Ajasin University, Akungba Akoko, Ondo State, Department of Microbiology, Faculty of Science and Department of Pharmaceutical Science (Natural product chemistry), Faculty of Pharmacy, Obafemi Awolowo University, Ile Ife, Osun State, Nigeria for their support and all the technical assistance rendered during the course of this research work.
The author declares that there is no conflict of interests involved in this study.

©2018 Osuntokun, et al. This is an open access article distributed under the terms of the, which permits unrestricted use, distribution, and build upon your work non-commercially.